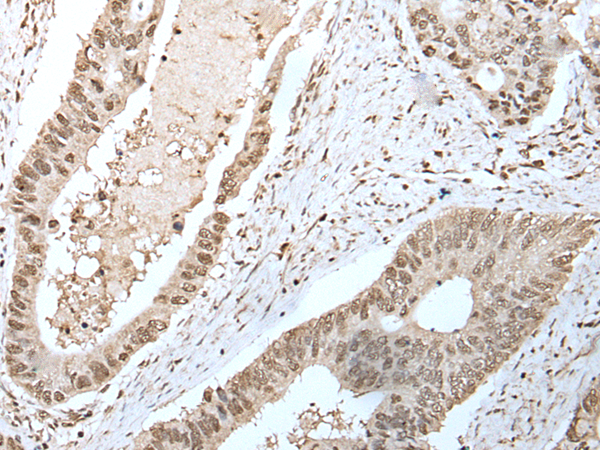

中文名稱: 兔抗U2AF2多克隆抗體
|
Background: |
U2 auxiliary factor (U2AF), comprised of a large and a small subunit, is a non-snRNP protein required for the binding of U2 snRNP to the pre-mRNA branch site. This gene encodes the U2AF large subunit which contains a sequence-specific RNA-binding region with 3 RNA recognition motifs and an Arg/Ser-rich domain necessary for splicing. The large subunit binds to the polypyrimidine tract of introns early during spliceosome assembly. Multiple transcript variants have been detected for this gene, but the full-length natures of only two have been determined to date. |
|
Applications: |
ELISA, IHC |
|
Name of antibody: |
U2AF2 |
|
Immunogen: |
Fusion protein of human U2AF2 |
|
Full name: |
U2 small nuclear RNA auxiliary factor 2 |
|
Synonyms: |
U2AF65 |
|
SwissProt: |
P26368 |
|
ELISA Recommended dilution: |
5000-10000 |
|
IHC positive control: |
Human esophagus cancer |
|
IHC Recommend dilution: |
25-100 |

購物車
幫助
021-54845833/15800441009
